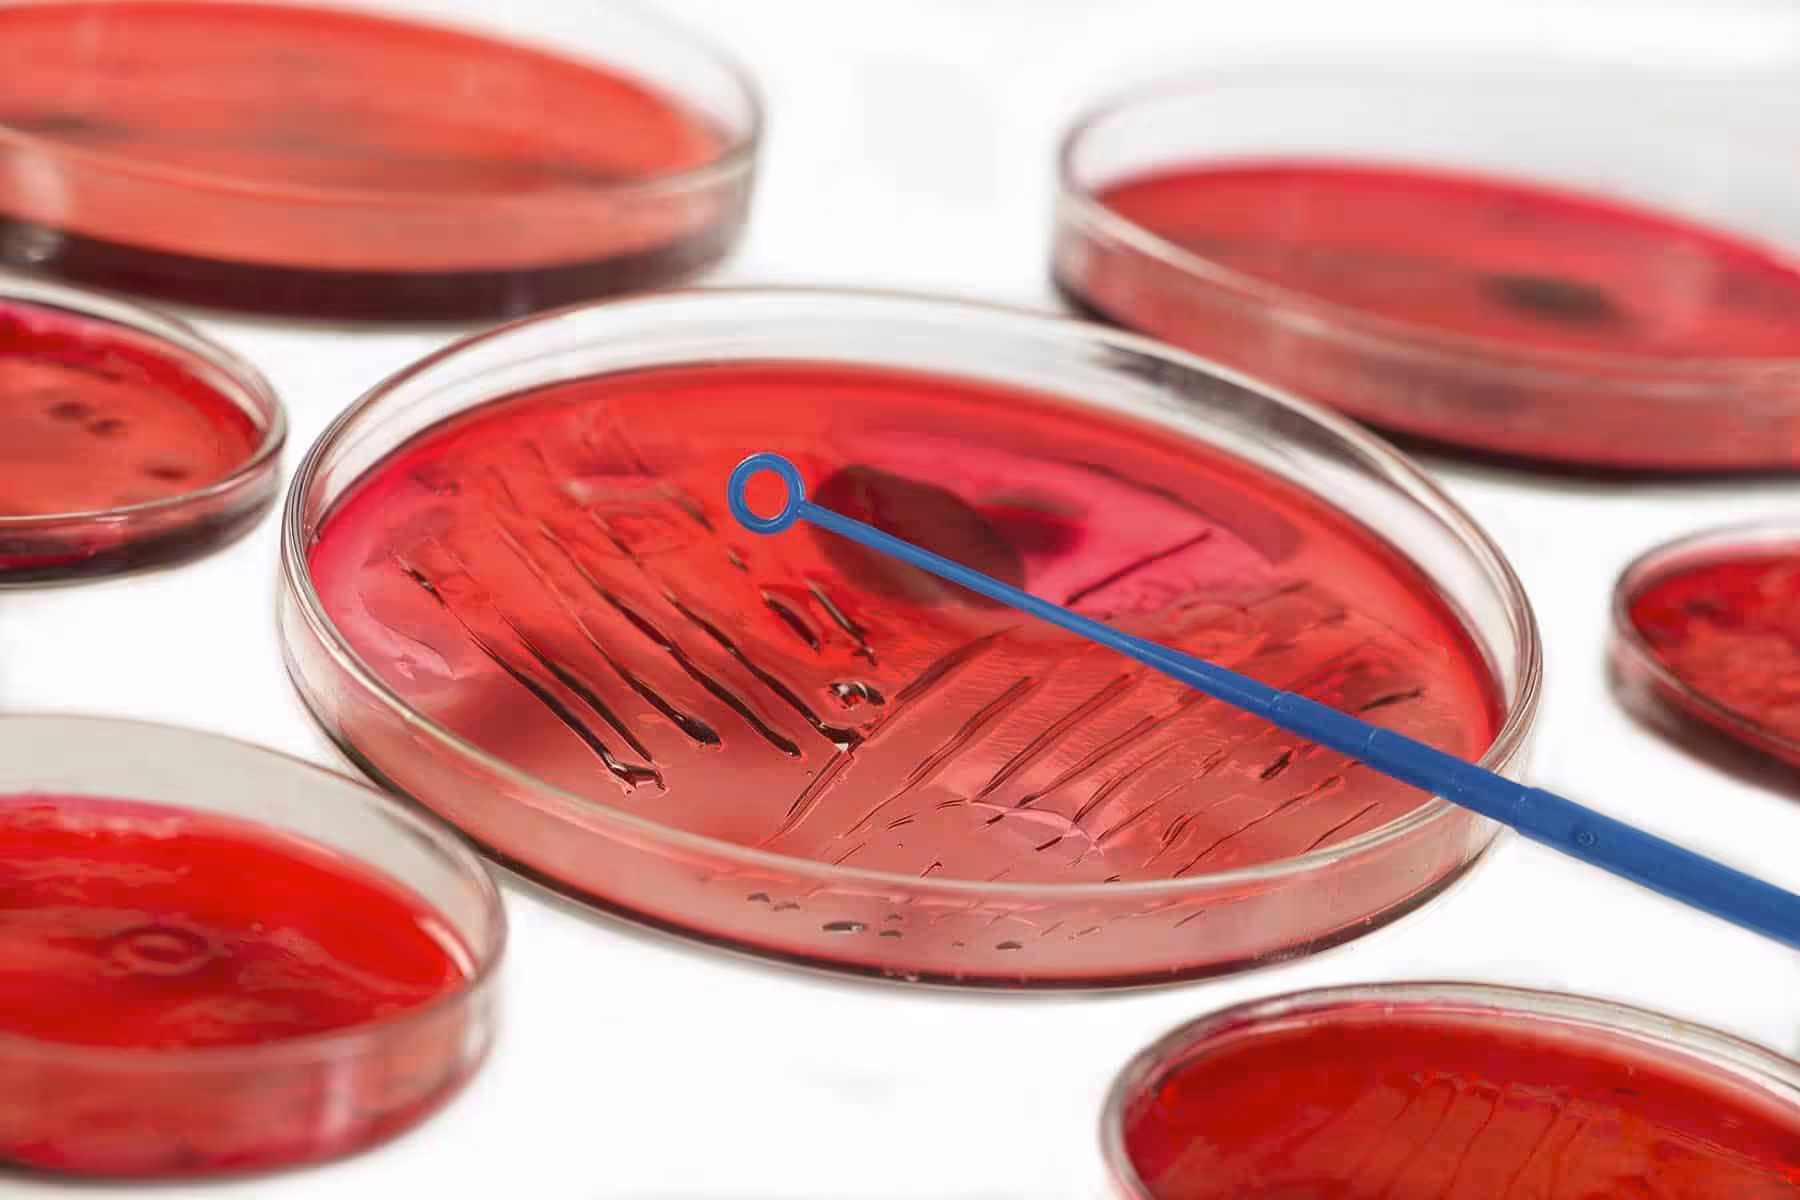

Bir “Beta” virüsüdür tutturulmuş gidiyor. Oysa beta denen şey bir bakteridir, virüs değil.
A grubu beta hemolitik streptokok! İşte halk arasında BETA mikrobu denen bakterinin tıbbi adı. Biz bu mikroba kısaca streptokok diyoruz. Streptokok farenjit, tonsillit (bademcik iltihabı) kızıl, yılancık ve impetigo denen bir cilt enfeksiyonlarının etkenidir. (Bu arada bakteri ve virüs nasıl ayrılır, isteyen bunu da okusun)
Beta bakterisinin yaptığı enfeksiyonlar:
Çocuklarda Kızıl Hastalığı
Streptokokların yol açtığı bulaşıcı döküntülü hastalığa kızıl denir. Kızılın aşısı yoktur. Birçok çocuk hastalığının aksine ilaç ile tedavi edilir. En çok 4 -10 yaş arası çocuklarda görülür. Kış aylarında daha sık rastlanır. Solunum yolu ile bulaşan streptokok hem boğazda farenjit veya bademcik enfeksiyonu yapar hem de salgıladığı toksinle bir döküntüye neden olur. Çocukta daha önce geçirdiği enfeksiyonlar nedeniyle hem bu bakteriye hem de toksinine karşı bağışıklık geliştiyse kızıl geçirmeyebilir.
Çocuklarda kızıl hastalığının seyri nasıldır?
Mikrobun alınmasından ortalama 2 – 4 gün sonra yüksek ateş, boğaz ağrısı, kusma, boyun ve göğüs üst kısmından başlayan döküntü olur. Ciltte kırmızı zeminli, dokunmakla ince zımpara kâğıdı hissi veren, basmakla solan döküntü tipiktir. Başlangıçta dil beyaz, üzeri paslıdır: Beyaz çilek dili. Sonra dil parlak kırmızı hal alır: Kırmızı çilek dili. Dirsek iç kısmı ve kasık gibi kıvrıntılı yerlerde daha koyu renkli çizgi şeklinde olur. Boğazda ağrı ağızda pis iltihaplı koku, öksürük, yoğun ateş, kırıklık, baş ağrısı, boyunda ağrılı lenf bezi büyümesi hastalığın diğer belirtilerdir.
Çocuklarda kızıl teşhisi nasıl konur?
Hastalığın tipik cilt bulguları ve boğaz görünümü ile tanı koyulması kolaydır. Şüpheli vakalarda boğaz kültürü alınır. Boğaz kültüründe beta bakterisi üremesi beklenir.
Çocuklarda kızıl tedavisi nasıl olur?
Beta hemolitik streptokok enfeksiyonu olan kızılın tedavisi mutlaka 10 gün antibiyotikle yapılmalıdır. Beta hemolitik streptokoklar antibiyotiklere çok hassas olup tedavi başlar başlamaz düzelme ortaya çıkar. Ancak iyileştiği sanılarak antibiyotik tedavisi yarıda bırakılırsa 100 kızıllı hastadan 5 – 10’unda kalp romatizması ortaya çıkar. (Bkz Akut Romatizmal Ateş)